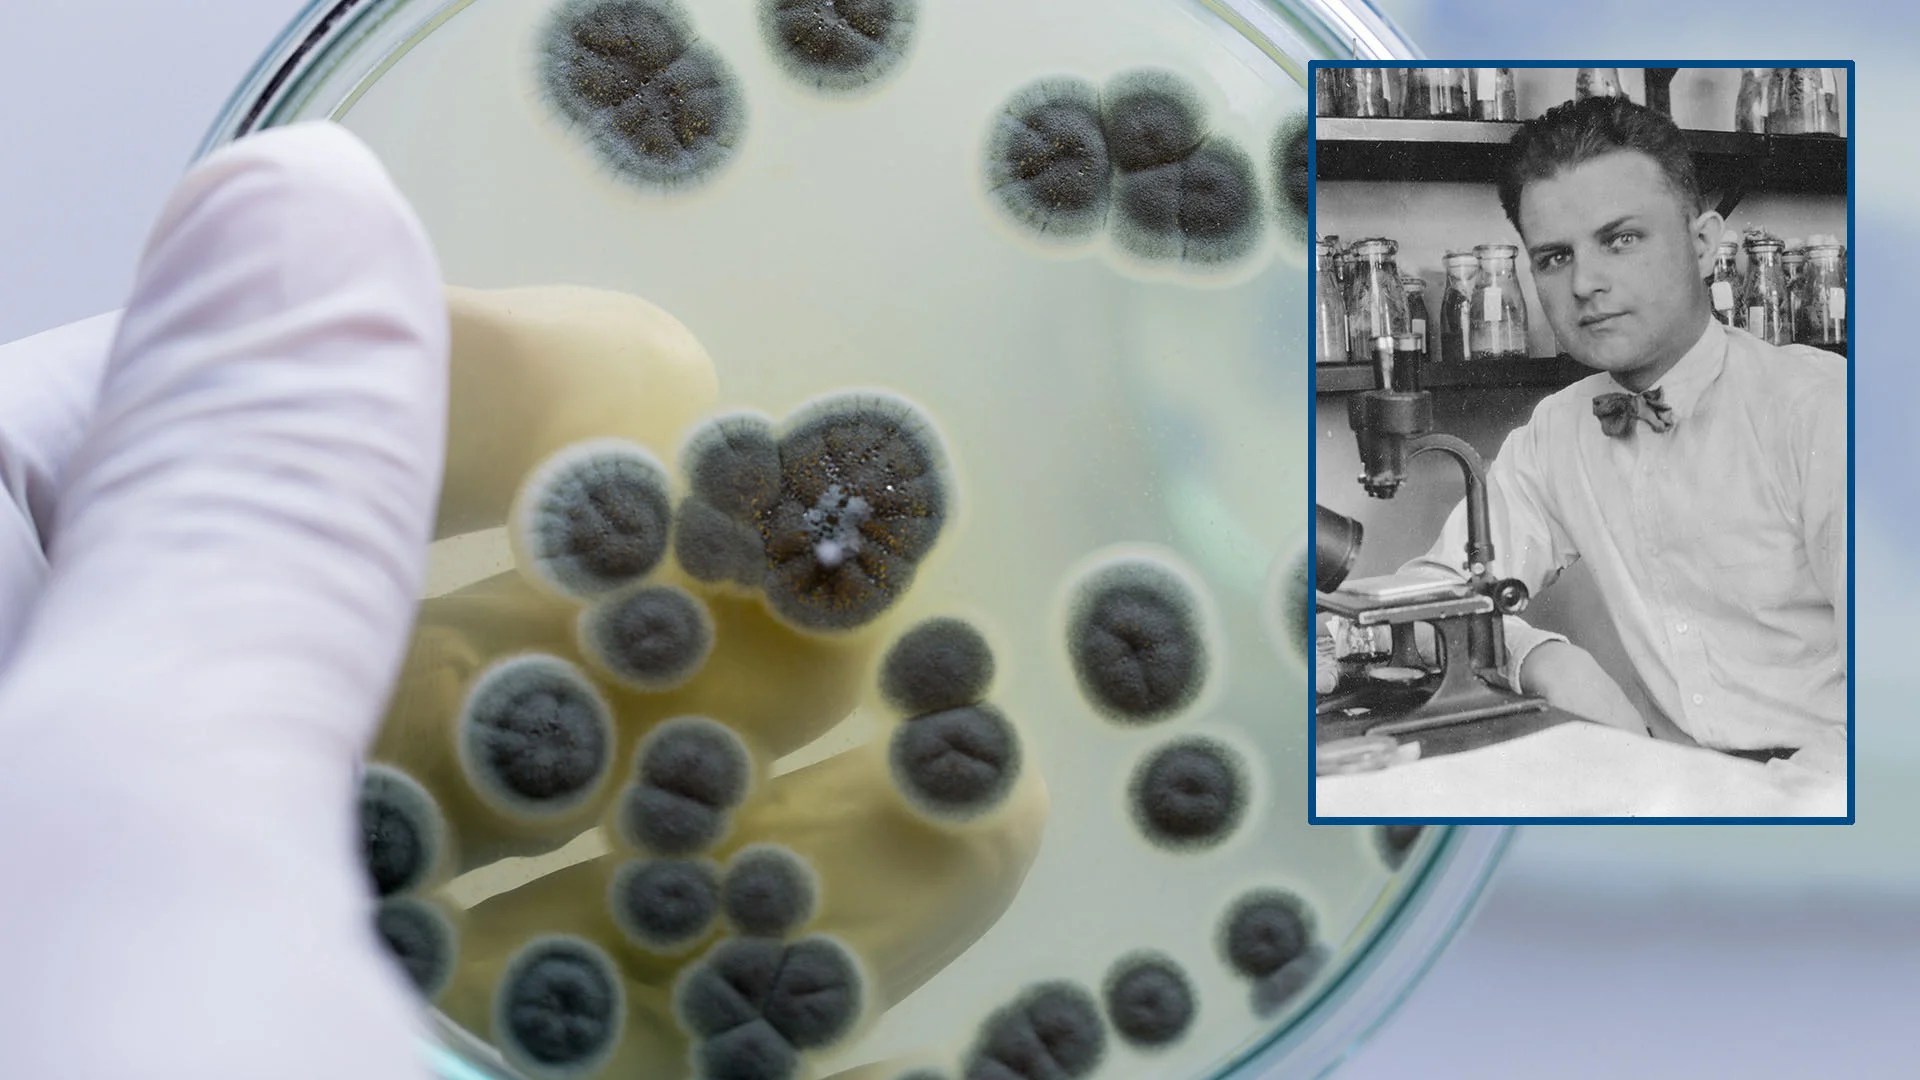

Penicillin was an antibacterial mould unearthed by Alexander Fleming, a Scottish physician and microbiologist, as a cure for bacterial infections in 1928.
People have sought to discover the most effective way to treat bacterial infections from ancient to modern times. They have found and used materials such as fungi and mould during their research. However, they failed to detect the correct component that people could use for medicine. Joseph Lister (1827-1912), an English surgeon, is known to be the first to identify the antibacterial character of mould. In the 1870s, German and French biologists ranging from Robert Koch (1843-1910) to Louis Pasteur (1825-1895) proposed the germ theory. According to this theory, certain bacteria were the reason for illnesses. This theory also ensured that bacteria could prevent mortal bacteria from growing if we implemented them in various cultures. Alexander Fleming’s discovery of a benign mould accompanied this theory. A continuous study went hand in hand with coincidence in his discovery.
Lysozyme before Penicillin
Fleming worked in hospitals on the Western Front as a Royal Army Medical Corps member during World War I (1914-1918). While he was doing his duty, he witnessed that wounded soldiers caught sepsis and died because of it. He also found that the Lister Antisepsis system including the application of antiseptics like iodine and carbolic did not sufficiently clean all detrimental bacteria. Moreover, it was one of the reasons for increasing the casualty rate among soldiers since it harmed therapeutic characteristics. Fleming issued an article in an edition of the Lancet in 1917, suggesting that the frontline doctors used antiseptics with more concentrated saline solution. However, they ignored him.
Fleming kept his studies after the war. In 1921, he experimented and discovered that human secretions such as nasal mucus, semen and blood had an antibacterial property, which he called lysozyme, inhibiting bacterial development. He shared his conclusions with the British science circles, but they ignored him again.
The Emergence of Penicillin and Afterwards
Lysozyme was the first antibiotic which Fleming discovered. However, it was not the only one, the second one was on the way. On September 3, 1928, Fleming noticed an area without bacteria because of a mould secreting an antibacterial substance in one of his Petri dishes containing Staphylococcus. He concluded that this mould killed that bacterium and continued studying. Consequently, he found that this mould could also kill bacteria such as Streptococcus, Meningococcus, and diphtheria.
The next step would be to produce this antibiotic plentifully to help as many people recover from bacterial infections as possible. Fleming saw that making this antibacterial substance in a pure form and a considerable amount was difficult. Nevertheless, he began the production with his means even if it was in a small quantity.
Meanwhile, a group of scientists at Oxford University devoted themselves to overcoming the obstacles to this new substance’s production on a larger scale. They found the correct structure of penicillin. They also offered to use water to make changes in its acidity rate.
Then it came to detect the new antibiotic’s toxicity degree. The scientists injected some animals with it and confirmed its efficiency during World War II (1939-1945). For instance, Howard Florey (1898-1968) and Ernst Chain (1906-1979) found that half a group of diseased mice healed when they gave them this new antibiotic.
Scientists also experimented with the substance on people. Fleming used it to cure a nasal infection, but he could not. However, one of his students, Cecil George Paine (1905-1994) managed to cure and treat conjunctivitis by deploying this antibiotic in November 1930. In the 1940s new trials on children with bacterial infections showed its success.
World War II (1939-1945) increased the necessity for this antibacterial substance. Since the Germans attacked London where the production centre was, the Allied powers moved it to Illinois. Then the United States and Great Britain concentrated on the mass production of penicillin. In the summer of 1943, a laboratory assistant named Mary Hunt discovered that the rotten cantaloupe contained a mould, later called Penicillium Chrysogenum. This meant being possible to produce the necessary antibacterial substance on considerable scales. Hence, production began climbing steadily after Hunt’s finding and it allowed frontline doctors of the Allied powers to treat many injured soldiers joining the Normandy landings against the Axis powers in June 1944.
Consequences
Therefore, Fleming’s antibacterial substance led to several important consequences for human health. Firstly, the proportion of bacterial infections became 20 times less than that during the previous World War. Secondly, the substance prepared the ground for other antibiotics that brought about the development of the medical health and pharmaceutical drug industry. Finally, Fleming’s antibiotic and subsequent ones elevated the average life expectancy in many countries, particularly developed ones in the 20th century. They also stopped contagious illnesses such as smallpox, cholera and tuberculosis from the leading causes of death1.
Tarihenotdus | Tarih, Kültür ve Medeniyetler sitesinden daha fazla şey keşfedin
Subscribe to get the latest posts sent to your email.